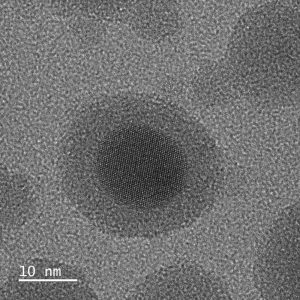

Ein leises Surren geht von dem Gerät aus. Drei hochauflösende Bildschirme zeigen die fremdartigen Oberflächen verschiedener Proben in millionenfacher Vergrößerung. Bereits Ende 2021 lieferte ein japanischer Hersteller das 1,5 Millionen Euro teure Supermikroskop als Bausatz nach Luxemburg. Bis es im Labor des LIST in Belval zusammengebaut, getestet und justiert worden war, vergingen jedoch mehrere Monate. „Das macht deutlich, mit was für einem komplexen Gerät wir es hier zu tun haben“, sagt Nathalie Valle von der „Advanced Characterization Platform“ am LIST. Fast wirkt der gut drei Meter hohe Aufbau, als hätte Mr. Spock ihn direkt vom Raumschiff Enterprise dort hingebeamt: Metallisch schimmernde Komponenten, eingehüllt in eine strahlend weiße Verkleidung. Davor eine elegante Konsole mit silbernen Knöpfen und Reglern.
Weiter reichen die Parallelen zur schillernden Science-Fiction Hollywoods jedoch nicht. Während die Forschenden in Film und Fernsehen meist schon nach wenigen Minuten Arbeit mit bahnbrechenden Erkenntnissen aufwarten können, erfordert die „Science-Reality“ deutlich mehr Ausdauer und Hingabe: „Die Untersuchung einer einzigen Probe kann über einen Tag in Anspruch nehmen. Und oft müssen wir für ein einziges Forschungsprojekt über Monate hinweg Dutzende Proben analysieren“, sagt Adrian-Marie Philippe.

Schon gewöhnliche Lichtmikroskope, wie sie auch im Schulunterricht zum Einsatz kommen, ermöglichen faszinierende Einblicke in eine verborgene Welt. Sie machen Details sichtbar, die das Auflösungsvermögen des menschlichen Auges weit übersteigen: Strukturen, die bis zu 500-mal kleiner sind, lassen sich damit erkennen. Doch für den Einsatz in der modernen Wissenschaft reicht das schon lange nicht mehr aus. Die Forscher müssen tiefer blicken – nicht nur, um Neues zu entdecken, sondern auch, um die Ergebnisse ihrer eigenen Arbeit überprüfen zu können.
Möglich macht das am LIST in Belval seit wenigen Monaten ein sogenanntes Transmissions-Elektronenmikroskop, kurz TEM. Während bei optischen Mikroskopen Licht und Glaslinsen zum Einsatz kommen, um das Untersuchungsobjekt zu vergrößern, verwendet das TEM Strahlen. Diese bestehen aus hochenergetischen Elektronen, die über elektromagnetische Linsen fokussiert werden. Da die Elektronen eine viel kürzere Wellenlänge haben als die Photonen im sichtbaren Licht, werden Strukturen sichtbar, die über 500.000-mal kleiner sind als die kleinsten Objekte, die ein Mensch mit bloßem Auge erkennen kann.
Was das Mikroskop den Forschern verrät
Als Forscher am LIST ist Adrian-Marie Philippe für den Betrieb und die Wartung des Elektronenmikroskops verantwortlich. Täglich analysiert er die verschiedensten Proben – von neuartigen Materialien für 5G-fähige „Nanodevices“ über Nanopartikel für Gassensoren bis hin zu Gummi-Mischungen für Autoreifen. „Die mikroskopischen Aufnahmen des TEM erlauben es den Forschern, wichtige Erkenntnisse über die chemischen und physikalischen Eigenschaften der Materialien zu erlangen, an denen sie forschen“, erklärt er. Nur auf diese Weise sei es den Wissenschaftlern möglich, zu verifizieren, inwiefern ein Material tatsächlich die Anforderungen erfüllt, die für eine spezifische Anwendung erforderlich sind. „Bei einem Autoreifen können Nanopartikel im Gummi beispielsweise einen entscheidenden Einfluss auf die Hafteigenschaften und den Verschleiß haben.“
Philippe öffnet eine der Aufnahmen, die er kürzlich mit dem TEM angefertigt hat: Aus Sicht eines Laien ist auf dem Graustufen-Bild zunächst nicht viel zu erkennen. Eine wirre Ansammlung dunkler Punkte; an einigen Stellen recht geordnet, an anderen wild durcheinander. Erst die Erläuterung des Experten macht klar: Jeder dieser Punkte entspricht einem einzelnen Atom. „Durch das TEM können wir tatsächlich sehen, wie die Atome und Moleküle in der Probe angeordnet sind, also ob sie etwa eine Kristallstruktur besitzen“, sagt Philippe. „Kein anderes Mikroskop in Luxemburg war bislang dazu in der Lage.“
Nathalie Valle ergänzt: „Der große Vorteil eines TEM gegenüber anderen modernen Mikroskop-Technologien ist zudem, dass wir damit praktisch jedes beliebige Material untersuchen können – egal ob biologisch, metallisch, Verbundmaterial oder Polymer. Daher können wir es in den verschiedensten Forschungsbereichen einsetzen.“ Durch zusätzliche Messungen kann das TEM sogar bestimmen, aus welchen chemischen Elementen die verschiedenen Bereiche des Materials bestehen.
Umfangreiche Vorbereitungen nötig
Doch bevor die Materialien den Wissenschaftlern ihre verborgenen Geheimnisse preisgeben, muss Philippe sie umfangreich präparieren: Mithilfe von Spezialequipment schneidet er Scheibchen von dem Material ab, die 1000-mal dünner sind als ein Blatt Papier. Nur so können die Elektronen, die das Mikroskop aussendet, die Probe durchdringen und auf dem dahinterliegenden Fotosensor ein Bild des Materials erzeugen. Einige Proben müssen zudem geschliffen, schockgefroren oder auf einen Trägerfilm aufgetragen werden, bevor sie untersucht werden können. „Die Vorbereitung nimmt mit Abstand die meiste Zeit in Anspruch. Die Aufnahme selbst ist mit einem Tastendruck erledigt“, so Philippe. Etwa zwei bis drei Proben analysiert er auf diese Weise pro Woche.
Bislang steht das TEM nur den Wissenschaftlern des LIST zur Verfügung. Doch schon bald soll es auch externen Forschungseinrichtungen und Partnern aus der Industrie möglich werden, ihre Proben von Adrian-Marie Philippe unter dem Mikroskop analysieren zu lassen. „Wir wollen, dass möglichst viele anwendungsorientierte Forschungsprojekte – und damit auch ganz Luxemburg – von unserem neuen Equipment profitieren können.“
So funktioniert das Transmissions-Elektronenmikroskop
Eine Elektronenquelle an der Oberseite des Mikroskops erzeugt freie Elektronen. Diese werden mit einer Spannung von bis zu 200.000 Volt auf fast 70 Prozent der Lichtgeschwindigkeit in Richtung der Probe beschleunigt. Die Elektronenstrahlen durchdringen das Material, wobei sie einander überlagern. Durch diese Wechselwirkung entsteht hinter der Probe ein exaktes Abbild, das von mehreren elektromagnetischen Linsen vergrößert und auf einen Kamera-Sensor geworfen wird. Damit die Elektronen auf ihrem Weg nicht mit Luftteilchen zusammenstoßen, herrscht im Inneren des Mikroskops ein extremes Vakuum.

 Zu Demaart
Zu Demaart

Sie müssen angemeldet sein um kommentieren zu können